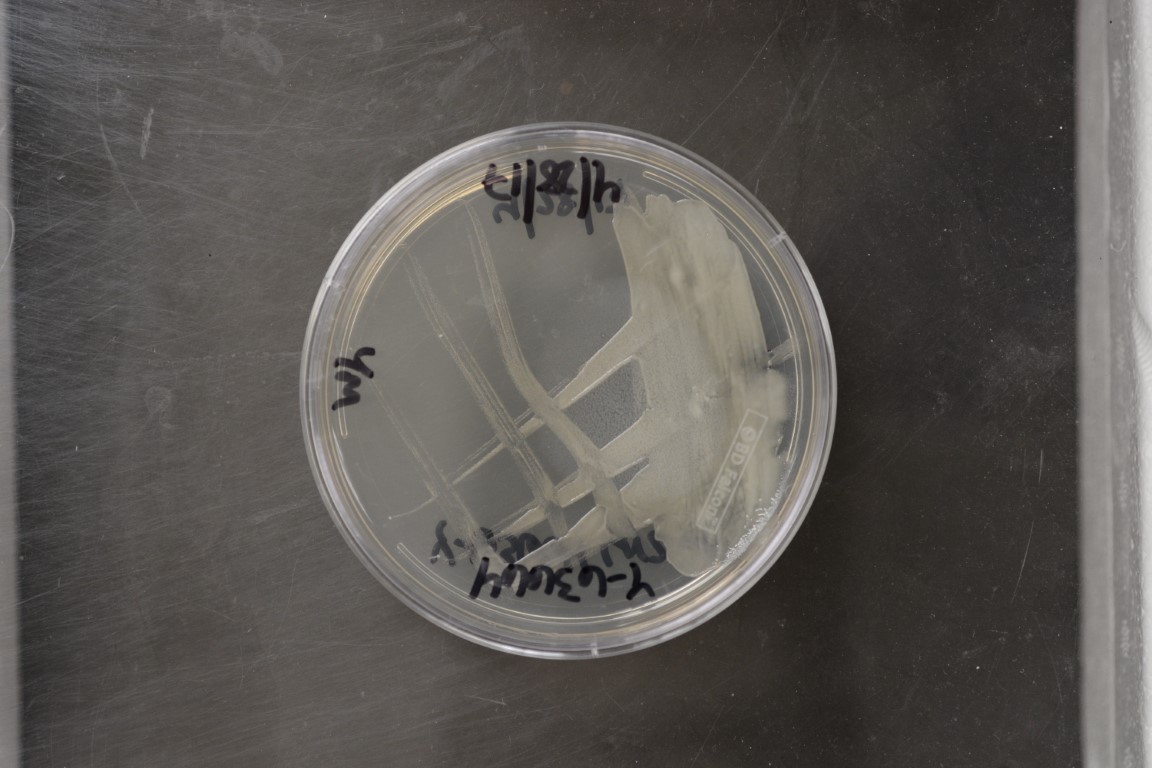

Tortispora cuajiniquilana
NRRL Y-63664(Type Strain)
Accession numbers in other collections:CBS 12796=UWOPS 99-344.4
Source:Cletus P.Kurtzman,NCAUR<--Andre Lachance for collaborative research
Isolated from(substrate):CAC,columnar cactus
Substrate location:Cuanjiniquil Beach,Guanacaste,Costa Rica
Genetic info:GenBank:D1/D2(KC681897).
Growth media:Yeast Extract-Malt Extract-Peptone-Glucose(YM for yeasts)(number 6)
Optimum growth temperature:25C
Strain images:
NRRL_Y-63664_6.JPG
 Comments:MycoBank number MB 803505.
Comments:MycoBank number MB 803505.